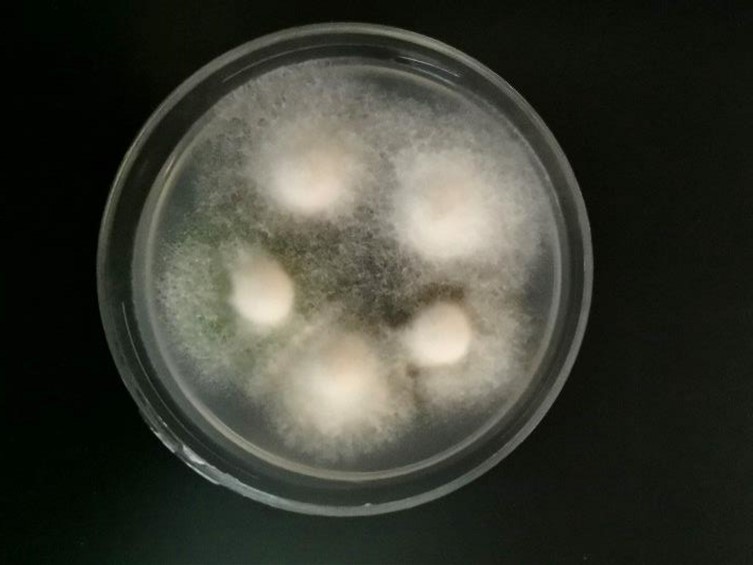

Holotype:
THAILAND, Trang Province, Khao Ban That Wildlife Sanctuary, 19 Mar. 2007, K. Tasanathai, S. Mongkolsamrit, P. Srikitikulchai, R. Promharn, T. Chohmee, holotype BBH 19860, ex-type living culture BCC 25100.
Habitat:
In leaf litter.
Host:
Adult cicada (Hemiptera, Megapomponia).
Description:
 Host covered by mycelium, initially white, then turning pale green to greyish green, with heavy sporulation. Synnemata absent. Conidiophores borne on hyphae, erect, septate, smooth-walled, hyaline, bearing divergent, terminal, verticillate metulae or
Host covered by mycelium, initially white, then turning pale green to greyish green, with heavy sporulation. Synnemata absent. Conidiophores borne on hyphae, erect, septate, smooth-walled, hyaline, bearing divergent, terminal, verticillate metulae or  phialides. Metulae broadly clavate or cylindrical. Phialides oval cylindrical, ellipsoidal, 4-8 × 3-4 μm.
phialides. Metulae broadly clavate or cylindrical. Phialides oval cylindrical, ellipsoidal, 4-8 × 3-4 μm.  Conidia aseptate, smooth-walled, cylindrical, ellipsoidal, usually slightly curved or allantoid, 6-11 × 3-5 μm.
Conidia aseptate, smooth-walled, cylindrical, ellipsoidal, usually slightly curved or allantoid, 6-11 × 3-5 μm.
Culture characteristics:
Colonies on PDA attaining a diam of 15 mm in 14 d, mycelium floccose, cottony greyish green to dark green, margin floccose, white, reverse centre yellow to yellow brown, sporulation starts at 7 d after inoculation. Conidiophores arising from hyphae, erect, smooth-walled, metulae broadly clavate. Phialides solitary or in groups of three to eight per metula, borne directly on the conidiophores, smooth-walled, oval-cylindrical, 5–10 × 3–4 μm. Conidia smooth-walled, hyaline, cylindrical to ellipsoidal, 7–13 × 3–4 μm.
Colonies on PDA attaining a diam of 15 mm in 14 d, mycelium floccose, cottony greyish green to dark green, margin floccose, white, reverse centre yellow to yellow brown, sporulation starts at 7 d after inoculation. Conidiophores arising from hyphae, erect, smooth-walled, metulae broadly clavate. Phialides solitary or in groups of three to eight per metula, borne directly on the conidiophores, smooth-walled, oval-cylindrical, 5–10 × 3–4 μm. Conidia smooth-walled, hyaline, cylindrical to ellipsoidal, 7–13 × 3–4 μm.
Reference:
Mongkolsamrit S, Khonsanit A, Thanakitpipattana D, et al. (2020). Revisiting Metarhizium and the description of new species from Thailand. Studies in Mycology 95: 171–251.
DOI: https://doi.org/10.1016/j.simyco.2020.04.001Species |
Strain |
Compound |
Pubchem CID |
Biological activity |
Reference |
|---|
|
Strain |
ITS | LSU | RPB1 | RPB2 | SSU | TEF1 |
|---|---|---|---|---|---|---|
| BCC 25100 | MN781906 | MN781847 | MN781751 | MN781799 | MN781947 | MN781702 |